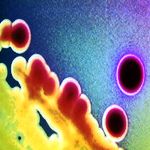
Ужасные выводы антивирусной лаборатории

Блог
Статьи
Новости магазина
-
 Вышла новая версия Handy Backup Server – программы резервного копирования данных, как на сервере, так и на рабочих станциях.
Вышла новая версия Handy Backup Server – программы резервного копирования данных, как на сервере, так и на рабочих станциях. -

Корпоративный щит - Kerio WinRoute Firewall
25.01.2008Kerio WinRoute Firewall 6.4.2 - надежный корпоративный файрвол для компаний малого и среднего бизнеса. -
 В этой логической головоломке вас ждeт продолжение увлекательной истории, которая началась в игре «Маджонг Артефакт».
В этой логической головоломке вас ждeт продолжение увлекательной истории, которая началась в игре «Маджонг Артефакт». -

Новые цены на интернет-магазин PHPShop
25.01.2008Цена на скрипт магазина стала сравнима с диском игры для приставки PS3. -

Готовые "Шаблоны календарей 2008"
25.01.2008В комплект входит 30 шаблонов высокого качества. -

Potolook ускоряет работу в Outlook
25.01.2008Potolook - это надстройка (plugin, add-in) к почтовому клиенту Microsoft Outlook (не Express), значительно упрощающая работу. -
 Paragon Partition Manager 8.5 Server Edition + Technician License 1 Year - простое в использовании решение для системных администраторов, технических...
Paragon Partition Manager 8.5 Server Edition + Technician License 1 Year - простое в использовании решение для системных администраторов, технических... -

Обои ко Дню Святого Валентина
24.01.2008"Озеро Влюбленных" - новые Анимированные Обои, посвященные дню Святого Валентина. -
 ABViewer — просмотрщик графических файлов, позволяет работать не только с растровыми (более 20 форматов), но и с векторными форматами файлов.
ABViewer — просмотрщик графических файлов, позволяет работать не только с растровыми (более 20 форматов), но и с векторными форматами файлов. -

Простое оформление почтовых переводов
24.01.2008Программа «Почтовые переводы» предназначена для оформления почтовых переводов по формам 112эф, 112эю (от 1 мая 2007 г.) и 112э. -

Трехмерная "Google Планета Земля"
23.01.2008С помощью Google Планета Земля Про можно легко изучать географические объекты и отображать найденные вами данные. -

Универсальные "Шаблоны зимних открыток"
23.01.2008Вышел набор открыток - высококачественная коллекция поздравительных открыток на тему «Зима». -

NiceLabel - печать и оформление этикеток
23.01.2008NiceLabel — позволяет создавать и выводить на печать на принтерах любого типа штрихкоды и RFID-метки. -
Ужасные выводы антивирусной лаборатории
22.01.2008Лаборатория Panda Security обнаружила, что количество новых вирусов, появившихся в 2007 году, выросло в 10 раз по сравнению с прошлым... -

Auslogics Visual Styler - стилист для ПК
22.01.2008Auslogics Visual Styler 3.1 заменит скучный экран загрузки и настроит приветствие с помощью сотен тем. -

Одна голова хорошо, а две - Dynamic Notes
22.01.2008Dynamic Notes 3.28 - простая напоминалка и менеджер записок для дома и офиса. -

"Загадки Эльдорадо" - азартная головоломка
22.01.2008"Загадки Эльдорадо" представляет собой механизм «собери тройку». -

Контроль записи на USB/CD/DVD
22.01.2008Обновилась программа для контроля доступа компьютеров локальной сети к внешним накопителям информации - FileControl 1.1. -

Простая игра для ясных мыслей
21.01.2008Пятнашки Z — классический вариант популярной головоломки, придуманной ещe в 1878 году. -

Эксклюзивные "Шаблоны современных открыток"
21.01.2008Программа представляет собой оригинальную коллекцию современных поздравительных открыток высокого качества.


























